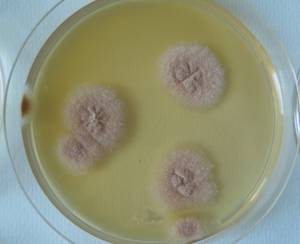
MSU_FS-02544 01, Район Кон Плонг (Kon Plông district), Kon Tum province (Vietnam)

Total items: 6
Total pages: 1
Organisms

- Specimen ID
- 0000001189720
- Species
- Aspergillus cervinus
- Strain
- MSU_FS-03264
- Place of isolation
- Район К Банг (K'Bang districts), Gia Lai province (Vietnam)
- Placename
- Кронг (Kroong (K'Rong) commune)
- Specimen ID
- 0000000905548
- Species
- Aspergillus cervinus
- Strain
- MSU_FS-02544
- Place of isolation
- Район Кон Плонг (Kon Plông district), Kon Tum province (Vietnam)
- Placename
- Манг Кань (Măng Cành commune)

- Specimen ID
- 0000000905114
- Species
- Aspergillus cervinus
- Strain
- MSU_FS-02155
- Place of isolation
- Район Ба Ви муниципалитета Ханой (Ba Vì district of Hanoi), Hanoi (Vietnam)
- Placename
- Ба Ви (Ba Vì commune)

- Specimen ID
- 0000000905076
- Species
- Aspergillus cervinus
- Strain
- MSU_FS-02136
- Place of isolation
- Район Бу Зяп (Bù Gia Mập district), Bình Phước province (Vietnam)
- Placename
- Бу Зя Мап (Bù Gia Mập)

- Specimen ID
- 0000000904568
- Species
- Aspergillus cervinus
- Strain
- MSU_FS-01634
- Place of isolation
- Район Лак Дыонг (Lạc Dương district), Lâm Đồng province (Vietnam)
- Placename
- Да Чайс (Đạ Chais)

- Specimen ID
- 0000000903832
- Species
- Aspergillus cervinus
- Strain
- MSU_FS-00978
- Place of isolation
- Район Лак Дыонг (Lạc Dương district), Lâm Đồng province (Vietnam)
- Placename
- Да Чаис (Đạ Chais)